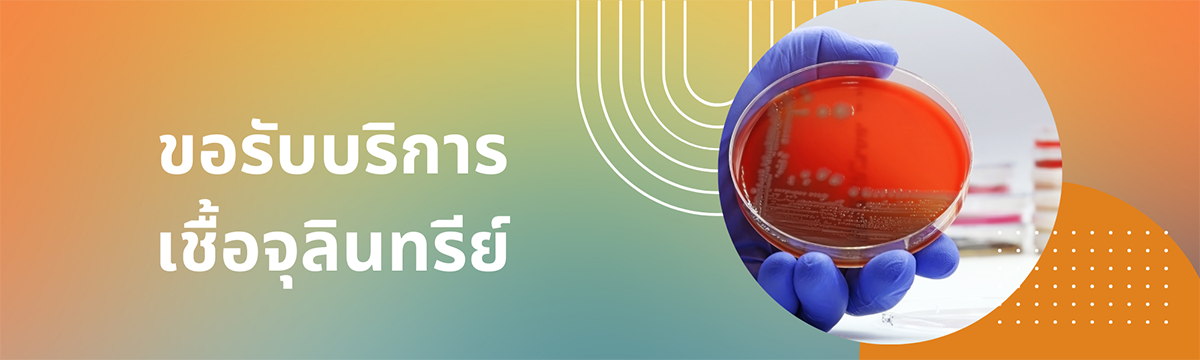

การขอรับบริการเชื้อจุลินทรีย์เกี่ยวข้อง
แผนผังเว็บไซต์
- ประวัติความเป็นมา
- ภารกิจ และหน้าที่รับผิดชอบของหน่วยงาน
- วิสัยทัศน์และพันธกิจ
- นโยบายคุณภาพ
- แผนกลยุทธ์กรมวิทยาศาสตร์การแพทย์
- แผนการปฏิบัติราชการ และแผนการใช้จ่ายงบประมาณ
- โครงสร้างหน่วยงาน
- หน่วยงาน
-
- ศูนย์ทรัพยากรชีวภาพทางการแพทย์
- ศูนย์จีโนมด้านโรคติดเชื้อ
- กลุ่มตอบโต้ภาวะฉุกเฉินทางห้องปฏิบัติการและเฝ้าระวังสายพันธุ์เอชไอวี
- กลุ่มพันธุกรรมทางคลินิก
- กลุ่มทรัพยากรกลางทางห้องปฏิบัติการสถาบัน
- กลุ่มสัตว์ทดลอง
- กลุ่มไวรัสวิทยาทางการแพทย์
- กลุ่มภูมิคุ้มกันวิทยา
- กลุ่มแบคทีเรียวิทยาทางการแพทย์
- กลุ่มเชื้อราวิทยาและพาราสิตวิทยา
- กลุ่มพิษวิทยาและชีวเคมี (ศูนย์พิษวิทยา)
- กลุ่มกีฏวิทยาทางการแพทย์
- สำนักงานอาชีวอนามัยและสุขภาพบุคลากร
- สำนักงานวิเทศสัมพันธ์
- สำนักงานระบบคุณภาพและความปลอดภัย
- กลุ่มพัฒนาคุณภาพและวิชาการ
- ฝ่ายบริหารทั่วไป
- ทำเนียบผู้บริหาร
- ซีไอโอ
- รายงานประจำปี
- กฏหมาย ระเบียบ และข้อบังคับที่เกี่ยวข้อง
Modal title
...